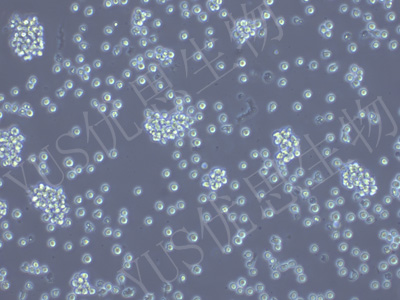

产品中心
产品中心
-

GCIY 人胃癌细胞(STR鉴定)
货号:YLH468规格: 1*10^6 -

IM95m 人胃腺癌细胞(STR鉴定)
货号:YLH469规格: 1*10^6 -
P3HR-1 人B淋巴瘤细胞(STR鉴定)
货号:YLH470规格: 1*10^6 -

H9 人胚胎干细胞(STR鉴定)
货号:YLH471规格: 1*10^6 -

SW872 人脂肪肉瘤细胞(STR鉴定)
货号:YLH472规格: 1*10^6 -

H1 人胚胎干细胞(STR鉴定)
货号:YLH473规格: 1*10^6 -

DYR0100 人诱导型多能干细胞(STR鉴定)
货号:YLH474规格: 1*10^6 -

MDA-MB-175VII 人乳腺导管癌细胞(STR鉴定)
货号:YLH475规格: 1*10^6 -

SW1088 人脑星形胶质瘤细胞(STR鉴定)
货号:YLH476规格: 1*10^6 -

SW1417 人结肠直肠腺癌细胞(STR鉴定)
货号:YLH477规格: 1*10^6 -

SW1463 人大肠癌细胞(STR鉴定)
货号:YLH478规格: 1*10^6 -

SW1573 人肺泡细胞癌细胞(STR鉴定)
货号:YLH479规格: 1*10^6
在线咨询
Online consultation

关注微信公众号


